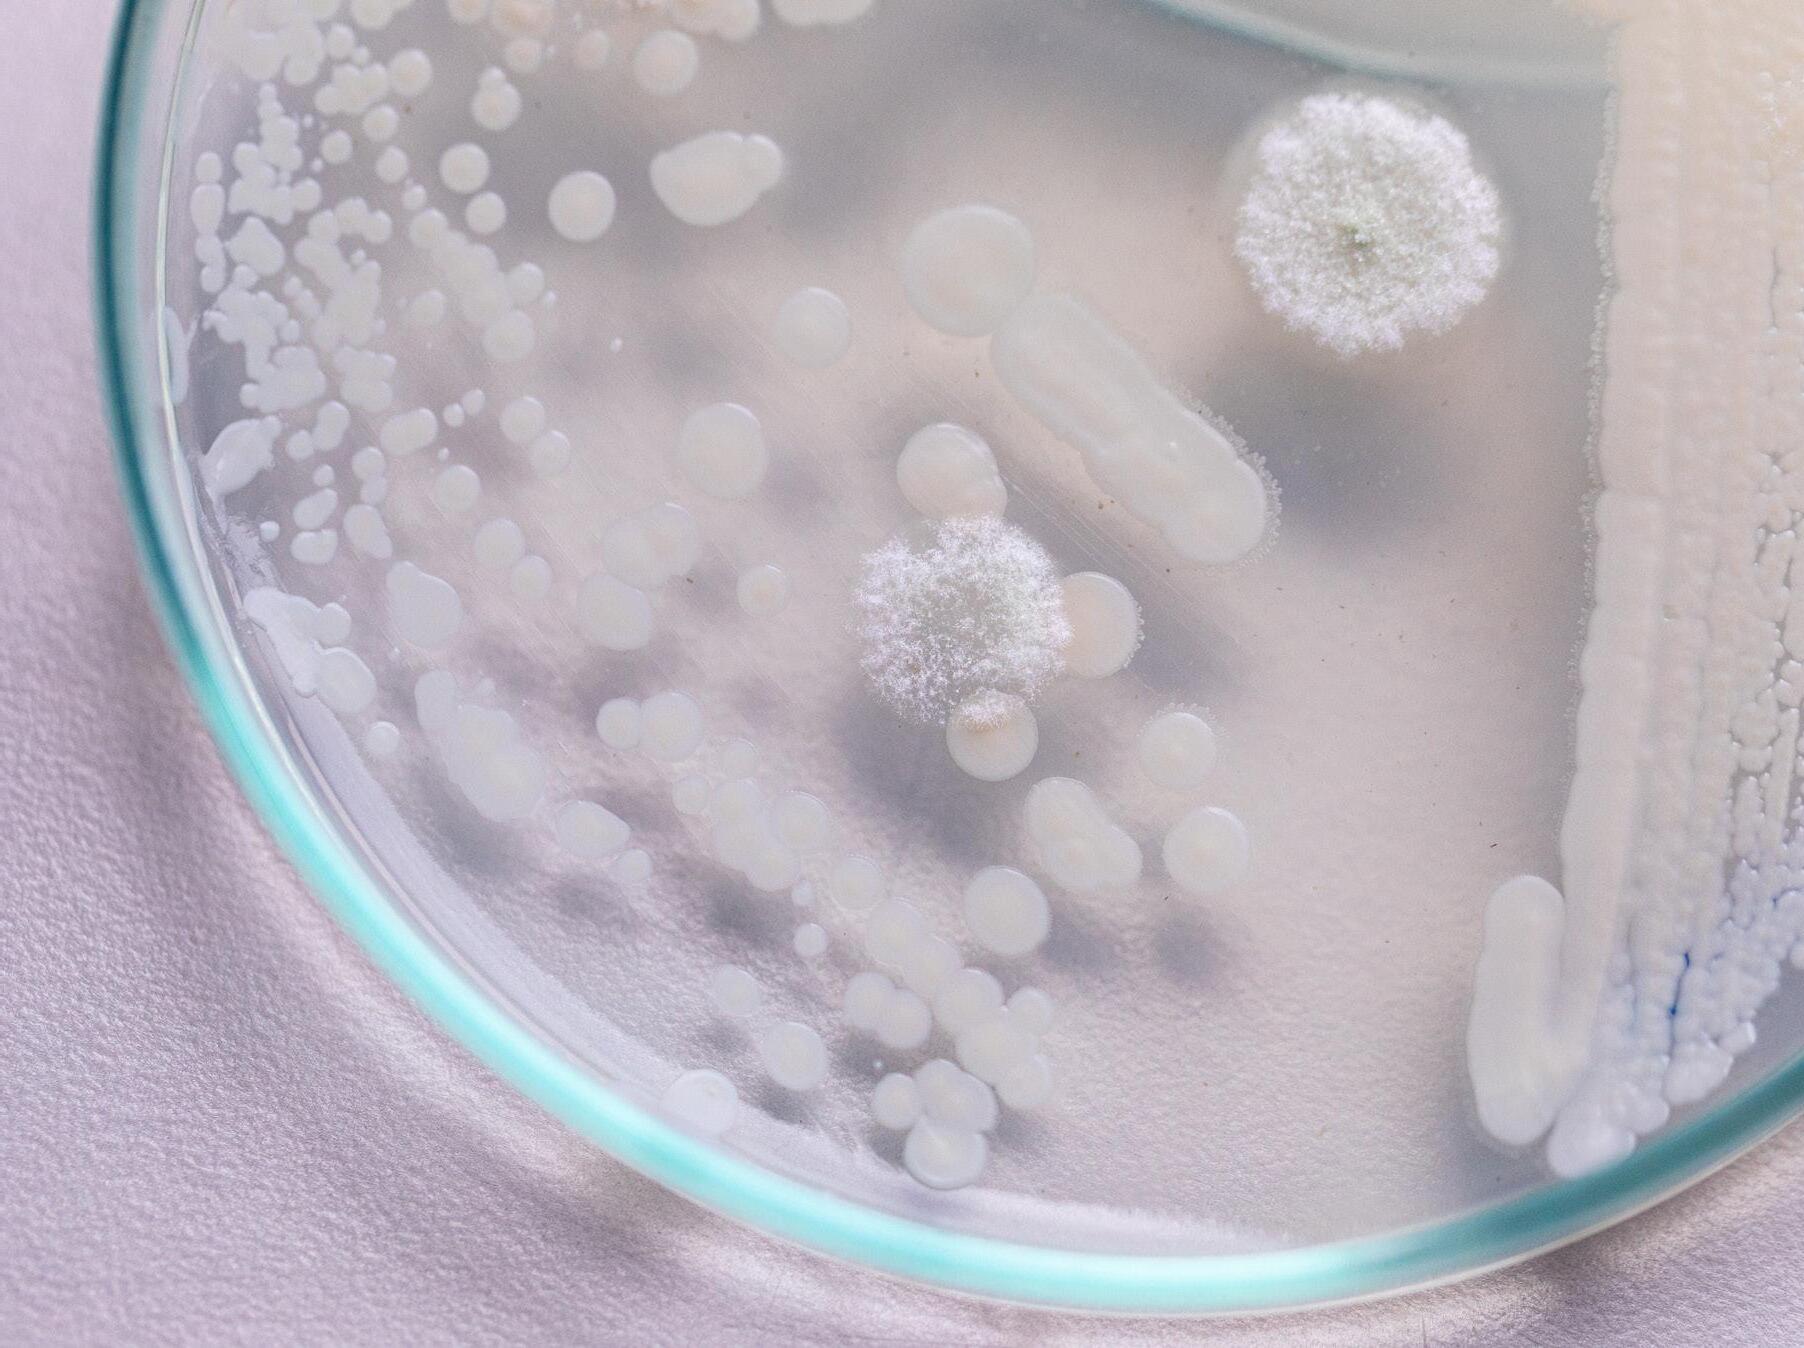

Annual Report 2024
Pushing the boundaries of science with an entrepreneurial spirit
![]()
Annual Report 2024
Pushing the boundaries of science with an entrepreneurial spirit
VIB is a leading life sciences research institute with an entrepreneurial spirit. We are a vibrant, multidisciplinary, and inclusive community of highly skilled scientists.
At VIB, curiosity drives us to push the boundaries of science, expanding our insights into life and transform it for the better. 16
68
VIB researchers pursue bold ideas to discover disruptive insights that push science forward and increase our fundamental understanding of life.
90
A thriving research environment is essential for attracting outstanding scientists and experts, driving scientific breakthroughs, and fostering innovation.
108
Sustainability goes beyond environmental responsibility. It encompasses the full impact of any activity on people and nature.
VIB, established in 1995, is a non-profit organization with a clear focus on scientific excellence and technology transfer.

At VIB, we are committed to pushing the boundaries of scientific discovery. Scientific excellence remains at the core of our mission. Our researchers study the molecular fundamentals of life, uncovering insights into disease mechanisms and plant biology. Their work lays the foundation for real-world impact and paves the way for innovative medical treatments and sustainable agricultural solutions.
As we reflect on 2024, we are pleased to highlight some of the many scientific breakthroughs that were accomplished by our research community across a wide variety of disciplines.
We revealed how the menstrual cycle influences breast cancer risk, we built synthetic nanopores that pave the way for tailored biosensors, and we refined microbiome biomarkers for colorectal cancer diagnosis. In addition, we discovered that, similar to people, plants go through a form of ‘puberty’ and with a little help from AI, we uncovered some of the secrets of beer flavors. This annual report showcases these and many other milestones.
This year, we strengthened our research environment by investing in cutting-edge technologies, and we merged VIB conferences and training into one solid program to foster knowledge exchange and career growth. Our Grand Challenges Program tackled pressing health and environmental issues, from new approaches in cancer treatment to sustainable agriculture. Through translational research, we advanced breakthroughs in immunology, neuroscience, and microbiology, ensuring that scientific discoveries move beyond the lab. VIB’s Innovation & Business team plays a crucial role in bridging the gap between science and society. By fostering partnerships, launching spin-offs, and licensing intellectual property, we are ensuring that groundbreaking research leads to tangible solutions.
This year, VIB successfully launched new biotech ventures, despite a challenging investment climate. Our growing network of bio-incubators in Ghent, Leuven, and Brussels provides start-ups with the infrastructure and support needed to scale their innovations. Through these initiatives, we are strengthening Flanders’ position as a key hub for life sciences and biotechnology.
VIB remains dedicated to responsible and ethical research. In animal studies, we continue to refine models and maximize the data derived from each experiment, reducing the number of animals needed while improving the quality of insights. Sustainability is also a growing priority, with concrete steps taken to minimize our environmental footprint and integrate eco-conscious practices into our daily operations.
The success of VIB is built on the dedication of our scientists, support staff, and partners. We take this opportunity to acknowledge every researcher, collaborator, and stakeholder who contributed to another year of remarkable achievements. By fostering curiosity and embracing bold ideas, we are shaping a future where science transforms lives.
Ajit Shetty, Chairman of the Board of Directors
Christine Durinx & Jérôme Van Biervliet,
Managing Directors
VIB is a leading life sciences research institute with an entrepreneurial spirit. We are a vibrant, multidisciplinary, and inclusive community of highly skilled scientists.
Our researchers pursue bold ideas to discover disruptive insights that push science forward and increase our fundamental understanding of life.
Our mission goes beyond the lab. We foster a collaborative environment and proactively team up with ambitious entrepreneurs to translate our scientific breakthroughs into innovative products and technologies for patients and society.
Our success relies on close collaborations with the universities in Flanders. Together, we create a vibrant research community that nurtures scientific excellence and makes a measurable impact on human and environmental health.
14 core facilities
Tech Transfer
€27.1 million total industrial income
2 new spin-offs
833 publications
266 publications in Tier 5 journals
90 PhD graduations
1 institute
5 partner universities
1,900 FTEs
96 research groups
78 nationalities
VIB stands for world-class research that translates into economic and societal value. For every €1 of core funding from the Flemish Government to VIB, €12 flows back to the economy of Flanders.
VIB has understood that it needs an effective innovation ecosystem in order to deliver its dual scientific and economic missions. VIB has recognized that if all parts of the system are not present and working well, the system as a whole will not deliver.
Graeme Blackett Director BiGGAR Economics
As a strategic research center, VIB is contracted by the Flemish Government to deliver both scientific and economic outputs. In line with that contract, an independent analysis is conducted every five years to map the quantitative and qualitative impact of VIB’s research and tech transfer efforts.
An independent analysis delves into typical drivers of economic impact, such as industry collaboration, start-up creation, and attracting international funding. This analysis also looks at broader societal impacts that improve the quality of life globally, assessing VIB’s societal contribution against an international framework, the OECD’s Better Life Index, and Flanders’ Transition Priorities (“Transitieprioriteiten”).
VIB has successfully nurtured multiple spin-offs, raising over €1.8 billion in investment. Several of these companies have been acquired by multinationals for a total of €4.5 billion, reinforcing VIB’s reputation as a driver of high-quality biotech startups.
For every €1 of core funding from the Flemish Government, VIB generates €12 for the Flemish economy. In 2023, VIB contributed nearly €1 billion in Gross Value Added and supported 11,000 jobs in Flanders.
A key factor in this success is VIB’s holistic approach to innovation, which goes beyond research and valorization to include infrastructure development and ecosystem building. By attracting international life sciences leaders, fostering top talent, and nurturing the next generation of biotech startups through initiatives such as biotopeby VIB, VIB has been a driving force behind the rapid growth of Flanders’ thriving biotech cluster.
€1.8B raised with multiple succesfully nurtured spin-offs
several acquired by multinationals for a total of €4.5B
€1
core funding from the Flemish Government
11,000 jobs in flanders
€1B
Gross Value Added
€12 for the flemish economy
Beyond its economic contributions, VIB’s activities drive meaningful societal benefits, particularly in healthcare, sustainable agriculture, and public engagement. Across its research, its Grand Challenges program focused on societal impact, and of course its spin-outs.
VIB has enabled:
⬛ New treatments for patients, e.g. through companies such as argenx, Ablynx, and Confo Therapeutics;
⬛ New diagnostic tests, e.g. for primary immunodeficiency, ovarian cancer, and colorectal cancer;
⬛ Bio-stimulant and bio-control technologies, e.g. through Aphea.bio and Biotalys, and sustainable legume crops through Protealis;
⬛ Community engagement, e.g. in citizen science and STEM outreach.
VIB plays a key role in advancing Flanders’ Transition Priorities by driving innovation across multiple sectors. In the circular economy, VIB collaborates with industry leaders like AB InBev and leverages biotechnologies such as yeast to enhance production efficiency, reducing energy consumption and material use. By attracting global talent and training a highly skilled workforce, VIB strengthens the biotech sector, aligning with Flanders’ vision for living, learning, and working in 2050.
Through Industry 4.0, VIB spin-offs integrate cutting-edge technologies, including AI and precision breeding, while benefiting from high-quality facilities like the Agro-Incubator. Lastly, VIB’s agricultural expertise contributes to sustainable land use and reduces reliance on harmful fertilizers and pesticides, supporting Flanders’ energy and climate goals.
At VIB, curiosity drives us to push the boundaries of science, expanding our insights into life and transform it for the better. Our researchers work across a wide range of disciplines, from cancer and inflammation to neuroscience and plant biology, continuously advancing our understanding of life’s fundamental processes. But knowledge alone is not enough. By translating scientific breakthroughs into real-world applications, we aim to contribute to better healthcare, more sustainable agriculture, and a stronger society.
VIB is home to ten specialized research centers, each focusing on a specific area of life sciences. These centers bring together experts who push the boundaries of their fields, collaborating across disciplines to address complex challenges. Through their dedication, we continue to build a foundation for innovation that benefits both people and the planet.
RESEARCH CENTER
Science directors
Diether Lambrechts
Jean-Christophe Marine
13 research groups 218 staff members
The VIB-KU Leuven Center for Cancer Biology (CCB) explores cancer initiation, progression, and metastasis, focusing on interactions between cancer cells and the tumor microenvironment. Its research highlights the micro-environment’s role in tumor heterogeneity, immune evasion, and therapy response. By identifying biomarkers for early detection and treatment monitoring, researchers at CCB contribute to more effective therapies. Committed to translational research, technology transfer, and starting up spin-offs, the center bridges scientific innovation with real-world applications, driving advancements in cancer treatment. Their work supports the development of combined therapeutic strategies, including immune checkpoint inhibitors and antiangiogenic treatments, targeting both tumor cells and their micro-environment.
Immune checkpoint blockade therapy has shown promise in cancer treatment, but not all patients respond effectively. A new study from the Laboratory of Translational Genetics has identified CD4+ T cells as a key predictor of treatment success in head and neck squamous cell carcinoma. Using single-cell genomics technologies, they discovered that patients who responded well to anti-PD-L1 immunotherapy already had active immune responses before treatment.
In contrast, combination therapy (anti-PD-L1 and anti-CTLA4) stimulated a new CD4+ T cell response independent of prior immune activation. These findings suggest a way forward for personalized and more effective care that starts by assessing the specific immune profiles of patients before initiating therapy.
Franken A., Bila M. et al., CD4+ T cell activation distinguishes response to anti-PD-L1+ anti-CTLA4 therapy from anti-PD-L1 monotherapy, Immunity
VIB Group Leader involved: Diether Lambrechts, VIB-KU Leuven Center for Cancer Biology
Other research groups involved: labs from KU Leuven, UZ Leuven, UZ Gent, Zhejiang University (CN), University of Calgary (CA)


Every month, breast tissue undergoes small structural changes as part of the menstrual cycle. But this routine process may have an unexpected consequence: allowing mutant cells to persist and spread, subtly increasing the risk of breast cancer over time.

In our study, we observed the evolution of mutant cells before they developed into cancer. More specifically, we labelled both healthy and mutated stem cells in the mammary tissue of mice and tracked their behavior over several months. Our findings showed that the menstrual cycle influenced the behavior of the labelled cells and allowed some of them to spread over large distances.
Colinda Scheele VIB Group Leader, VIB-KU Leuven Center for Cancer Biology
Despite breast cancer’s high prevalence, we still do not comprehend the complex mechanisms triggering its initial development. While healthy breast tissue appears normal, it often contains large fields of mutant cells capable of evolving into tumors. Understanding how these mutant cells spread within the tissue is crucial for uncovering the mechanisms behind cancer development.
A team of VIB researchers, in collaboration with colleagues in the Netherlands and UK, investigated how regular breast tissue remodeling during the menstrual cycle might contribute to cancer risk.
They revealed that the normal process of forming and removing milk-producing ducts each cycle plays a double role. While this process eliminates most unnecessary and mutant cells, a few mutated cells can evade clearance. These surviving cells then proliferate and expand within the tissue, gradually increasing the likelihood of cancer formation over time.
The study suggests that with each menstrual cycle, there is a small but cumulative risk of mutant cell expansion. It may also explain why factors like pregnancy and breastfeeding, which reduce the number of cycles, are linked to a lower risk of developing breast cancer.
This research provides new insights into how breast cancer may originate at a very early stage. The next step is to study human breast tissue samples to confirm these mechanisms. By uncovering how mutant cells spread within normal tissue, the findings open new avenues for potential clinical strategies for early intervention by disrupting the expansion of mutant cells before they develop into cancer.
Ciwinska M. et al., Mechanisms that clear mutations drive field cancerization in mammary tissue, Nature Group Leader: Colinda Scheele, VIB-KU Leuven Center for Cancer Biology
Other research groups involved: Labs from The Netherlands Cancer Institute (NL), UMC Utrecht (NL), and University of Cambridge (UK)

Immunotherapy has revolutionized cancer treatment, yet less than 50% of melanoma patients respond effectively. To tackle this challenge, the Laboratory for Molecular Cancer Biology studied melanoma samples in depth using advanced single-cell and spatial technologies. They identified a subset of rare mesenchymal-like cells that are resistant to immunotherapy. These cells depend on the TCF4 molecule to evade the immune system. By targeting TCF4 using existing drugs, the researchers could enhance the sensitivity to immunotherapy in preclinical models. This breakthrough offers a promising strategy for overcoming resistance and providing more effective treatments for melanoma patients who currently do not benefit from immunotherapy.
Pozniak J., Pedri D., Landeloos E. et al., A TCF4dependent gene regulatory network confers resistance to immunotherapy in melanoma, Cell
VIB Group Leader involved: Jean-Christophe Marine, VIB-KU Leuven Center for Cancer Biology
Other research groups involved: labs from KU Leuven, Ghent University, UZ Leuven, VIB Inflammation Research Center, University of Essen (DE), Yale University and University of California (US)
The VIB Center for Inflammation Research (IRC) studies the fundamental mechanisms of immunity and inflammation to improve disease prevention and treatment. While inflammation is vital for immune defense, chronic inflammation can drive disease. IRC scientists investigate how immune cells communicate and how barrier cells in the skin, lungs, gut, and brain function. By integrating advanced technologies and translational research, with several principal investigators also holding clinical roles, IRC bridges fundamental science and medical application. Through technology transfer and interdisciplinary collaboration, the center accelerates the development of novel therapies, bringing innovative treatments from the lab to clinical trials and beyond.
Science director
Bart
15 research groups
358 staff members
Colon cancer is a deadly cancer with rising incidence, especially among young people. Emerging evidence suggests that certain gut bacteria contribute to the development of cancer by producing colibactin, a toxin that damages DNA. Researchers have discovered that these bacteria bind to intestinal cells using a specific mechanism: protein fibers called pili that are capped by specific adhesin proteins FimH and FmIH.
The adhesion enables colibactin delivery and promotes tumor growth. Blocking this bacterial binding in preclinical models significantly reduced DNA damage and cancer progression, highlighting a potential new therapeutic strategy to prevent colon cancer.
Jans M., Kolata M., et al., Colibactin-driven colon cancer requires adhesin-mediated epithelial binding, Nature VIB Group Leaders: Lars Vereecke, VIB-UGent Center for Inflammation Research and Han Remaut, VIB-VUB Center for Structural Biology
Other research groups involved: labs from KU Leuven, UGent, Cancer Research UK Scotland Institute (UK), University of Glasgow (UK) and Cornell University (US)


Pyroptosis, a form of programmed cell death, has traditionally been viewed as purely inflammatory, helping to clear infections but also causing tissue damage. However, a new study from the Cell Clearance in Health and Disease Lab reveals that pyroptosis also promotes healing. The scientists found that pyroptotic cells release molecules such as prostaglandin E2 and other metabolites that induce gene expression changes in macrophages, enhancing tissue repair. These findings challenge current approaches to blocking pyroptosis in disease treatment and suggest that harnessing its healing factors could lead to new therapies for chronic wounds and inflammatory conditions.
Mehrotra P., Maschalidi S., et al., Oxylipins and metabolites from pyroptotic cells act as promoters of tissue repair, Nature
VIB Group Leader: Kodi Ravichandran, VIB-UGent Center for Inflammation Research
Other research groups involved: labs from UGent, Washington University in Saint Louis (US), University of Virginia (US), and ITMO University (RU).

Despite advances in treatment, multiple myeloma remains an incurable blood cancer with a high likelihood of relapse. The effectiveness of emerging immunotherapies depends on the state of the tumor-immune micro-environment, which plays a key role in disease progression and response to treatment. Scientists have now created an atlas of the multiple myeloma immune micro-environment across disease stages using single-cell RNA-sequencing. Their analysis revealed that disease progression leads to immune exhaustion, with neutrophils becoming pro-tumorigenic and dendritic cells losing activity.
Targeting dendritic cells successfully activated immune responses in preclinical models. Their findings highlight the atlas as a critical resource enabling patient stratification and guiding the development of durable immunotherapies for multiple myeloma.
Verheye et al. A single-cell transcriptomic map of the murine and human multiple myeloma immune microenvironment across disease stages, Journal of Hematology & Oncology
VIB Group Leader: Damya Laoui, VIB Center for Inflammation Research
Other research groups involved: labs from VUB, UZ Brussel, and UGent
The VIB-UGent Center for Medical Biotechnology (CMB) pioneers biomolecular analytics and biopharmaceutical engineering, with a strong focus on protein technology and innovative DNA and RNA readouts. By tackling key biomedical challenges, CMB develops innovative solutions for diagnostics, prognostics, and therapeutics.
With expertise in protein engineering, interactomics, proteomics, tumor (epi)genetics, glycomics, and bioinformatics, the center deciphers molecular processes and engineers living cells for targeted drugs and vaccines. Committed to technology transfer, CMB transforms discoveries into real-world applications. Through collaborations with biotech and pharmaceutical companies, their work has led to clinical trials and VIB start-ups, highlighting their impact on both medical science and industry innovation.
Science director Kris Geveart
7 research groups
135 staff members
The yeast Pichia Pastoris plays a valuable role in protein production across therapeutic and other biotechnology applications. However, the use of the basic Pichia strain has historically been restricted due to contractual and financial constraints. Therefore, VIB researchers have developed OPENPichia, a license-free version of this widely used expression system. By reverse genomic engineering of the commercial strain, the team established a suitable alternative strain and optimized it to produce proteins to industrial standards. OPENPichia will promote innovation in protein production using Pichia pastoris and in time, reduce the costs for protein production and drug development.
Claes K. et al., OPENPichia: licence-free Komagataella phaffii chassis strains and toolkit for protein expression, Nature Microbiology
VIB Group Leader involved: Nico Callewaert, VIB-UGent Center for Medical Biotechnology
Other research groups involved: Labs from UGent, VIB BioImaging Core and InBiose NV

The human immune system combats viruses by producing alarm proteins, named interferons, that activate antiviral defenses in cells such as interferon-stimulated genes. One such gene product, the MX2 protein, has long been known to restrict viruses like HIV-1 and herpes through unknown mechanisms. VIB scientists have now demonstrated that the MX2 protein assembles into biomolecular condensates that mimic nuclear pores — structures that viruses normally use to deposit their genome inside the nucleus. By creating these decoy structures, the MX2 protein can lure, trap, and puncture viruses. This discovery opens avenues for developing innovative antiviral therapies.
Moschonas G.D. et al., MX2 forms nucleoporin-comprising cytoplasmic biomolecular condensates that lure viral capsids, Cell Host & Microbe
VIB Group Leaders involved: Xavier Saelens and Sven Eyckerman, VIB Center for Medical Biotechnology
Other research groups involved: Labs from VIB Center for Medical Biotechnology, KU Leuven, UGent, VIB Bioimaging Core, and Hannover Medical School (DE)
RESEARCH DISCIPLINE
Neuroscience is a major research focus at VIB, with three dedicated centers working to unravel the complexities of the brain and nervous system. From decoding neural circuits to understanding the genetic basis of brain disorders, VIB scientists are tackling fundamental questions about how the brain functions and what happens when it goes wrong. Their expertise spans neurobiology, systems neuroscience, and neurogenetics, driving discoveries that could lead to new treatments for neurological diseases.
The VIB-UAntwerp Center for Molecular Neurology (CMN) is dedicated to understanding and improving treatments for complex neurodegenerative diseases affecting both the central and peripheral nervous system. With a dual focus on neurogenetics and neuroimmunity, the center investigates how genetic factors, and the immune system contribute to neuronal disease.
Science director
Rosa Rademakers
6 research groups 96 staff members
Their translational and integrative approach to neuroscience combines patient studies with multi-omics research — genetics, transcriptomics, proteomics, and metabolomics — to unravel disease mechanisms. By integrating molecular biology, immunology, bioinformatics, and clinical insights, they aim to map disease progression and identify therapeutic targets, using advanced biosampling and biometric testing to bridge the gap between research and treatment.
Frontotemporal lobar degeneration is a leading cause of dementia in adults under 65, often linked to genetic factors. The TMEM106B gene has been identified as a disease modifier, particularly in individuals with pathogenic variants in the GRN and C9orf72 genes. VIB researchers examined TMEM106B influences across different genetic forms of the disease. They found that the minor allele of TMEM106B was associated with greater gray matter volume in GRN carriers and improved cognitive scores in c9orf72 carriers. These findings underscore the role of TMEM106B in disease modification and the importance of considering TMEM106B genetic status in predicting disease symptoms and progression.
Vandebergh M. et al., Gene-Specific Effects on Brain Volume and Cognition of TMEM106B in Frontotemporal Lobar Degeneration, Neurology
VIB Group Leader: Rosa Rademakers, VIB Center for Molecular Neurology
Other research groups involved: labs associated with the ALLFTD Consortium

Alzheimer’s disease is a progressive neurodegenerative disorder that affects millions of people. Microglia, the brain’s immune cells, play a key role in the disease by reacting to amyloid plaques and driving neuroinflammation. However, studying microglia in human brain samples is challenging. To overcome this, scientists have developed a xenotransplantation mouse model using human microglia, enabling direct observation of their response to Alzheimer’s pathology. The study revealed that human microglia exhibit distinct immune responses compared to mice microglia, underscoring the need for human-relevant models for this disease. These findings can inform future microglia-targeted Alzheimer’s therapies.
Mancuso R. et al., Xenografted human microglia display diverse transcriptomic states in response to Alzheimer’s disease-related amyloid-β pathology, Nature Neuroscience
VIB Group Leader: Renzo Mancuso - VIB-UAntwerp Center for Molecular Neurology and Bart De Strooper, VIB-KU Leuven Center for Brain & Disease Research, University College London (UK)
Other research groups involved: labs from KU Leuven
Neuro-Electronics Research Flanders (NERF) is a partnership between KU Leuven and VIB, dedicated to unraveling brain function at every level — from individual cells and circuits to complex behaviors.
By merging neurobiology with nano-engineering, NERF develops cutting-edge electronic, chemical, and optical technologies to study the brain. The center pioneers large-scale neural recording and imaging techniques, including Neuropixels recordings, optical imaging, and functional ultrasound, to study and manipulate brain circuits with unprecedented spatial and temporal resolution. Additionally, NERF advances machine learning to analyze neural data, model brain systems, and push the boundaries of theoretical neuroscience.
49 staff members Science director Sebastien Haesler
6 research groups
The spinal cord is often seen as a passive relay between the brain and the body but there has been evidence for a long time that it can independently learn and remember movements. However, the specific neuronal mechanisms for this spinal learning have remained unclear. Researchers have now identified two distinct neuronal populations — dorsal neurons for learning and ventral neurons for memory — that enable spinal cord-based motor adaptation.
Their findings reveal that spinal circuits function autonomously in movement learning and offer new insights into motor control, discoveries that could inform rehabilitation strategies for individuals recovering from spinal cord injuries.
Lavaud S. et al., Two inhibitory neuronal classes govern acquisition and recall of spinal sensorimotor adaptation, Science
VIB Group Leader involved: Aya Takeoka, NERF
- KU Leuven and VIB


Marcigaglia S. et al., Microfluidic interfaces for chronic bidirectional access to the brain, Advanced Healthcare Materials
VIB Group Leader involved: Sebastian Haesler, NERF- KU Leuven and VIB
Other research groups involved: labs from KU Leuven and UGent
Delivering drugs to the brain is challenging due to the blood-brain barrier, which blocks most substances from entering the brain. Similarly, collecting cerebrospinal fluid for diagnostics is invasive and prone to contamination. Using two-photon polymerization, researchers created micronozzles attached to medical-grade tubing, allowing precise, minimally invasive fluid access. Compared to standard catheters, these microcatheters reduce backflow, improve drug distribution, and cause less brain disruption in rodent studies. This groundbreaking technology provides a powerful new tool for neurological research, offering a safer and more effective approach for studying brain diseases and testing new treatments.
The VIB-KU Leuven Center for Brain & Disease Research (CBD) unravels the basic mechanisms of neurobiology and explores brain diseases such as Alzheimer’s, ALS and Parkinson’s. Its research is structured around multidisciplinary themes that cross scales and disciplines, from synapse formation to neural circuits and behavior. CBD scientists explore brain development, aging, and repair, investigate how toxic protein assemblies affect cellular function, and examine how cell types, including neurons, microglia, astrocytes, and oligodendrocytes interact in healthy brains and in brain disease.
The research center is dedicated to translating discoveries into therapeutic strategies, working closely with technology transfer teams to ensure real-world impact. The center fosters a dynamic and diverse neuroscience community, where collaboration and knowledge exchange drive innovation at every level.
Science director
Patrik Verstreken
14 research groups
253 staff members

Alzheimer’s disease is marked by memory loss and cognitive decline. While amyloid plaques, formed from amyloid precursor protein, are a well-known hallmark of the disease, new research from the Laboratory for Membrane Trafficking highlights an earlier, overlooked mechanism. They discovered that APP-CTF, a specific amyloid precursor fragment, disrupts communications between the endoplasmic reticulum and lysosomes, impairing cellular calcium homeostasis and waste disposal. This dysfunction may occur much earlier, preceding plaques. The findings support a so-called ‘double-hit’ mechanism, wherein APP-CTF and amyloid peptide fragments chronically damage lysosomes, likely overlapping in early stages of Alzheimer’s. Therapeutic intervention to block the buildup of such proteolytic fragments could therefore be an early step in stopping or preventing Alzheimer’s disease.
Bretou M. et al., Accumulation of APP C-terminal fragments causes endolysosomal dysfunction through the dysregulation of late endosome to lysosome-ER contact sites, Developmental Cell
VIB Group Leader involved: Wim Annaert, VIB-KU Leuven Center for Brain & Disease Research
Other research groups involved: labs from KU Leuven, University of Toronto (CA) and University of Turku (FI)
Despite being crucial for health, the biology of sleep is still a mystery. While scientists have studied sleep through behavior and brain activity, little is known about what happens at the cellular level. Researchers at the Fly Sleep Lab used single-cell genomics in fruit flies to investigate how gene expression shifts throughout the sleep-wake cycle. Their findings reveal distinct changes in glial cells — non-neuronal brain cells — suggesting that these cells help regulate sleep by integrating signals related to sleep need and the body’s natural sleep-wake rhythm. This work provides a valuable data set for researchers to dig further into the cellular foundations of sleep.
Dopp J. et al., Single-cell transcriptomics reveals that glial cells integrate homeostatic and circadian processes to drive sleep-wake cycles, Nature Neuroscience VIB Group Leader involved: Sha Liu, VIB-KU Leuven Center for Brain & Disease Research

RESEARCH CENTER
At the VIB-KU Leuven Center for Microbiology (CfM), scientists explore the fascinating world of microorganisms. Microbes play a crucial role in the production of fermented foods, biofuels, medicines, and bioplastics; they sequester carbon from the atmosphere and serve as models for studying cellular processes in higher organisms.
Research at the center spans biotechnology, antimicrobial treatments, and industrial yeast development for applications ranging from foods and beverages to biofuels like bioethanol and beer production. Scientists also harness microbes to identify medically relevant genes and study pathogenicity, evolution, and antibiotic resistance and carbon sequestration. With a strong focus on innovation and sustainability, the center drives advancements in medicine, industry, and environmental management, fostering long-term industry collaborations and launching successful spin-offs.
Science director Kevin Verstrepen
5 research groups 112 staff members

The flavor of food arises from a complex interaction of many chemical compounds and external factors. To study flavor development and perception in a comprehensive and unbiased manner, scientists from the Lab for Systems Biology have developed AI models that predict the consumer appreciation of beers and identify aroma compounds that enhance flavor. The scientists first analyzed the chemical profiles of 250 beers and correlated them with evaluations from a trained human panel. By integrating AI, they were then able to predict key aromas and overall taste scores without human input.
They used this approach to improve an existing commercial beer by optimizing its aroma, as confirmed in blind tastings. The model’s potential extends to zero-alcohol beers as well as other food products offering a transformative tool for improving food products.
Schreurs M. et al., Predicting and improving complex beer flavor through machine learning, Nature Communications
VIB Group Leader involved: Kevin Verstrepen, VIB-KU Leuven Center for Microbiology
Other research groups involved: labs from KU Leuven, the Leuven Institute for Beer Research, VIB Technologies, AB InBev
For years, scientists have linked certain gut microbes to colorectal cancer, but what if some of these associations were misleading? By accounting for overlooked variables, researchers have reevaluated long-standing microbial biomarkers, challenging previous assumptions and uncovering new, more reliable indicators.

The human gut is home to trillions of microbes, influencing everything from digestion to immune function. In recent years, scientists have explored how the microbiome may also serve as a biomarker for cancers, including for colorectal cancer. While previous studies have identified microbial biomarkers linked to colorectal cancer, these studies relied on non-quantitative, descriptive methods that have led to concerns that these associations may be misleading.
In a new study, researchers set out to tackle these concerns by taking into account microbiome confounders and absolute quantification. They analyzed microbiome data from a wide cohort of patients in various stages of colorectal cancer and reexamined prior studies. Furthermore, they combined quantitative microbiome profiling and rigorous confounder control to reevaluate colorectalcancer-associated microbial biomarkers.
Their results were striking. Without adjusting for confounding variables, previously reported microbiome-colorectal cancer associations remained unchanged.

However, when factoring in key variables like gut transit time, fecal calprotectin levels and BMI, many well-known biomarkers such as Fusobacterium nucleatum were no longer significantly associated with the disease. Instead, the study uncovered robust associations with Anaerococcus vaginalis, Dialister pneumosintes, Parvimonas micra, Peptostreptococcus anaerobius, Porphyromonas asaccharolytica, and Prevotella intermedia, highlighting their potential as future targets for intervention.
These findings underscore the importance of rigorous methodologies and patient phenotyping when studying diseasemicrobiome associations. A refined colorectal cancer biomarker discovery approach could lead to more accurate, non-invasive diagnostic tools, reducing unnecessary colonoscopies and improving early detection strategies.
Tito R.Y. et al., Microbiome confounders and quantitative profiling challenge predicted microbial targets in colorectal cancer development, Nature Medicine
VIB Group Leader involved: Jeroen Raes, VIB-KU Leuven Center for Microbiology
Other research groups involved: labs from KU Leuven, Amsterdam University Medical Center (NL) and Janssen Pharmaceutica NV
This study shows we must separate the wheat from the chaff when studying cancerassociated biomarkers. By implementing confounder control and quantitative profiling, we were able to reveal potential misleading associations between microbial markers and colorectal cancer development, for example driven by intestinal inflammation.
Jeroen Raes VIB Group Leader VIB-KU Leuven Center for Microbiology
RESEARCH CENTER
The VIB-VUB Center for Structural Biology (CSB) unravels the structure and dynamics of macromolecular complexes to understand their role in health and disease. By combining X-ray crystallography, NMR spectroscopy, cryo-electron microscopy, and biophysical techniques, CSB pushes the boundaries of molecular and cellular biology.
A key breakthrough was the development of Nanobody® technology, which uses small camelid antibodies to stabilize challenging target proteins for structural studies—establishing VIB as a global leader in the field.
Science directors
Jan Steyaert
Han Remaut
9 research groups 115 staff members
CSB has a strong track record of translating fundamental discoveries into societal value, leading to spin-offs and industry-licensed technologies in drug development, nanopore sequencing, and bio-based material.
Transmembrane β-barrel pores are widely used in single-molecule DNA and RNA sequencing, enabling portable and pointof-care applications. However, existing nanopores are based on naturally occurring proteins, which limit sensor design. VIB scientists along with an international team of collaborators have developed a computational approach to design novel transmembrane β-barrel pores from scratch, creating stable, tunable nanopore channels with customizable properties. These synthetic nanopores demonstrated improved signal stability and were successfully used to detect smallmolecule metabolites. This breakthrough paves the way for tailored biosensors, offering potential advancements in diagnostics and molecular analysis beyond traditional lab-based methods.
Berhanu S., Majumder S. et al., Sculpting conducting nanopore size and shape through de novo protein design, Science
VIB Group Leader: Anastassia Vorobieva, VIB-VUB Center for Structural Biology
Other research groups involved: labs from UW Medicine (US), University of Virginia (US), HHMI (US), University of Leeds (UK) and University of Basel (CH)


The higBA toxin-antitoxin system helps Vibrio cholerae bacteria survive by controlling toxin activity and gene expression. Scientists believed that this regulation depended on well-structured protein-DNA interactions. However, new research reveals that HigA2, the antitoxin in this system, uses a flexible, disordered region to perform two distinct tasks: neutralizing the toxin HigB2 and dynamically binding to DNA to regulate DNA transcription. This challenges traditional models of bacterial gene regulation, revealing that protein disorder enhances specificity, mirroring mechanisms observed in more complex organisms. These insights open new avenues for understanding bacterial survival strategies and gene control.
Hadži S. et al., Fuzzy recognition by the prokaryotic transcription factor HigA2 from Vibrio cholerae, Nature Communications
VIB Group Leader: Remy Loris, VIB-VUB Center for Structural Biology
Other research groups involved: labs from VUB, University of Ljubljana (SI), Slovenian NMR Center (SI)
The VIB-UGent Center for Plant Systems Biology (PSB) addresses agricultural challenges by advancing research in sustainable bioenergy, climate-resilient crops, plant diversity, and innovative crop care. Scientists work on enhancing crop productivity, improving stress tolerance, analyzing plant genomes, and studying root-soil interactions. They also develop biomaterials, precision agriculture techniques, and plant-based pharmaceuticals.
Breakthroughs in plant genomics, molecular biology, and gene editing help unlock plants’ full potential. Systems biology provides a holistic view of plant interactions, driving innovations in agriculture. With rising global demand for plant-based products, PSB’s research supports food security, renewable energy, and industrial applications, leading to successful start-ups and industrial partnerships.
Science director
Yves Van de Peer
19 research groups
258 staff members
Clathrin-mediated endocytosis allows cells to internalize molecules and requires coordinated recruitment of dozens of proteins. The TSETTPLATE complex is crucial for this process in plants. A new study from the Laboratory of Advanced Live Cell Imaging shows that two disordered subunits, AtEH1 and AtEH2, act as scaffolds to drive biomolecular condensation, where proteins cluster into dynamic, dropletlike structures.
This process is triggered by interactions with membrane phospholipids and weak multivalent interactions that recruit clathrin and other proteins. Additionally, the amino acid composition of the intrinsically disordered region of AtEH1 regulates condensate strength and thereby endocytic dynamics. These findings highlight the conserved role of biomolecular condensation in endocytosis across eukaryotes.
Dragwidge J.M. et al., Biomolecular condensation orchestrates clathrin-mediated endocytosis in plants, Nature Cell Biology
VIB Group Leader involved: Daniël Van Damme, VIB-UGent Center for Plant Systems Biology
Other research groups involved: labs from Tsinghua University (CN), Université de Bordeaux (FR), Czech Academy of Sciences (CZ)



Brassinosteroids are essential plant steroid hormones that boost crop yields. They are synthesized inside cells but must function at the cell surface. However, how they are transported from inside the cell to the surface has remained unclear. Scientists from the Brassinosteroids Lab have now discovered that the ATP-binding cassette subfamily B19 (ABCB19), previously known only as an auxin transporter in Arabidopsis, also exports bioactive brassinosteroids. Using biochemical assays, genetic analysis and cryoelectron microscopy, they demonstrated the role of ABCB19 in exporting bioactive brassinosteroids to the cell surface for signaling. These findings open up new avenues for improving plant productivity and resilience via modulating brassinosteroid levels and distribution.
Ying W. et al., Structure and function of the Arabidopsis ABC transporter ABCB19 in brassinosteroid export, Science
VIB Group Leader involved: Eugenia Russinova, VIB-UGent Center for Plant Systems Biology
Other research groups involved: labs from UGent, University of Science and Technology of China (CN), Institute of Science and Technology (AT), The Czech Academy of Sciences and Palacký University (CZ)


Roots do more than just anchor plants — they actively adapt and transform as they grow. A new study reveals that, much like shoots, roots undergo a developmental transition that shapes their structure and function.

Our research not only presents a previously unknown fundamental mechanism of plant development, but it also opens new avenues for improved crop yields and plant resilience in
changing environmental conditions.
Bert De Rybel
VIB Group Leader VIB Center for Plant Systems Biology
Plants, like all living organisms, go through distinct developmental stages. From a tiny seed, they sprout into shoots and eventually become mature, fertile plants. During this process they undergo transitions that allow them to adapt to their environment, such as shifting growth patterns or changing how they use resources. For example, shoots undergo a kind of ‘puberty’, altering their growth direction to better survive external conditions.
But what about roots? Do they go through a similar transition beneath the soil? A new study reveals that roots experience their own version of puberty. Between the first and third week of development, roots undergo significant structural and molecular changes. SPL13, a transcription factor, plays a central role in this transformation by regulating the orientation of cell division. By shifting the way cells divide, SPL13 influences the overall structure of the root system.
Using advanced microscopy-based screening technology, the team identified molecules that alter cell division orientation in root cells.
Their findings showed that modifying SPL13 levels could change how roots grow, making them steeper and deeper. Remarkably, this even allowed the researchers to speed up or slow down root aging, opening possibilities for influencing plant development in controlled ways.
This study also reveals a gap in current plant research. Many experiments rely on root samples that are only one week old, yet these findings demonstrate that roots undergo significant changes as they develop, and studies focused on root development need to take this into consideration. Understanding SPL transcription factors and their impact on root growth could lead to new agricultural strategies aimed at increasing crop resistance to drought and other environmental challenges.
Yang B., Sun Y. et al., SPL13 controls a root apical meristem phase change by triggering oriented cell divisions, Science
VIB Group Leader involved: Bert De Rybel, VIB-UGent Center for Plant Systems Biology
Other research groups involved: VIB Screening Core, labs from UGent and the University of Chinese Academy of Sciences (CN)
RESEARCH CENTER
The VIB.AI Center for AI & Computational Biology pioneers AI-driven research to tackle complex biological questions. By combining advanced computational methods with experimental science, the center creates a unique ‘humid’ research environment where in silico models and laboratory experiments reinforce each other.
VIB.AI applies AI to a wide range of biological fields, from genomics, protein structure, and cellular functions to tissue dynamics, disease processes, and evolution. Its research focuses on representation learning, AI explainability, and hybrid modeling to deepen our understanding of biological systems.
With affiliated group leaders across all VIB research domains, VIB.AI connects fields such as microbiology, plant science, neuroscience, cancer biology, and immunology.
Science director
Stein Aerts
1 research groups
25 staff members
The liver carries out more than 500 essential tasks, yet how its primary functional cells, hepatocytes, develop specialized roles in different areas has long been unclear. Scientists now used a diverse array of techniques from single-cell multiomics, spatial omics, and deep learning to reveal that distinct liver cell function is encoded in gene regulatory networks. They identified transcription factors TCFL71 and TBX3 as key regulators of hepatocyte function and mapped enhancer-gene networks. Their deep learning model, DeepLiver, predicts DNA sequence effects, offering potential applications in enhancer gene therapy to target metabolic disorders.
Bravo Gonzalez-Blas C. et al., Single-cell spatial multi-omics and deep learning dissect enhancer-driven gene regulatory networks in liver zonation, Nature Cell Biology
VIB Group Leader involved: Stein Aerts, VIB.AI - VIB Center for AI & Computational Biology
Other research groups involved: labs from KU Leuven and the VIB-KU Leuven Center for Cancer Biology

Single-cell ATAC-sequencing (scATAC-seq) is a powerful tool for studying gene regulation, but differences between protocols can affect data quality and interpretation. Scientists have now systematically compared eight scATAC-Seq methods across 47 experiments, identifying key differences in data complexity, accuracy, and consistency that influenced how well each method identified cell types and genomic regulatory patterns.
To improve standardization, the scientists developed PUMATAC, a standardized data processing pipeline. They also established a reference set of differentially accessible regions to benchmark future studies. These findings provide a valuable reference for optimizing scATAC-seq studies and guiding technology selection in gene regulation research.

De Rop F. et al., Systematic benchmarking of single-cell ATAC-sequencing protocols, Nature Biotechnology
VIB Group Leader involved: Stein Aerts, VIB.AI - VIB Center for AI & Computational Biology
Other groups involved: labs from KU Leuven, Institut d’Investigacions Biomèdiques August Pi i Sunyer (ES), Centre for Genomic Regulation (ES), Broad Institute of MIT and Harvard (US), Stanford University (US), Gladstone Institute of Neurological Disease (US), Wellcome Sanger Institute (UK), Oregon Health & Science University (US)
Berlin Institute of Health at Charité–Universitätsmedizin Berlin (DE), Max Delbrück Center for Molecular Medicine (DE), École Polytechnique Fédérale de Lausanne (CH), Swiss Institute of Bioinformatics (CH), Universitat Pompeu Fabra (ES), Vitalant Research Institute (US), University of California San Francisco (US), University of Adelaide (AU), University of Melbourne (AU), Bio-Rad (US), Universitat de Barcelona (ES), Centro de Investigación Biomédica en Red de Cáncer (ES), Institució Catalana de Recerca i Estudis Avançats (ES), University of Cambridge (UK), Chan Zuckerberg Biohub (US), Koch Institute of Integrative Cancer Research (US), Howard Hughes Medical Institute (US)

The VIB International Grants Office supports researchers in securing competitive funding through personalized assistance, specialized training, and strategic resources. By enhancing grant success rates and facilitating prize nominations, the office helps maximize VIB’s research impact and international recognition.
Jan Steyaert, VIB-VUB Center for Structural Biology, has received Methusalem funding from the Flemish government. This prestigious program provides long-term structural financing to top researchers in universities, reducing reliance on external project-based funding.
We are proud to congratulate our VIB researchers on receiving prestigious awards in recognition of their outstanding scientific contributions.
Yvan Saeys, VIB-UGent Center for Inflammation Research, received an Essential Open-Source Software grant from the Chan Zuckerberg Initiative to develop nextgeneration cell-cell communication models.
Sarah-Maria Fendt, VIB-KU Leuven Center for Cancer Biology, received the AACR Award for Outstanding Achievement in Basic Cancer Research.
Two researchers at the VIB-KU Leuven Center for Brain & Disease Research were honored by the Queen Elisabeth Medical Foundation: Sriram Balusu was awarded the Ernest Solvay Prize, and Baptiste Libé-Philippot received the Prijs Marc Hurard.



Additionally, Xiao-Zheng Liu from the VIB-KU Leuven Center for Cancer Biology was awarded the Belgian L’Oréal-UNESCO For Women in Science Award 2024 for her important research into the metabolic evolution of cancer cells.
A number of VIB researchers received recognition for their work in various ways: Georg Halder, VIB-KU Leuven Center for Cancer Biology, was elected as EMBO member. Dirk Inzé, VIB-UGent Center for Plant Systems Biology, and Peter Carmeliet, VIB-KU Leuven Center for Cancer Biology, were elected as members of the European Academy of Engineering. And last but not least, Damya Laoui was named Commander of the Order of the Crown in recognition for her cancer research and outreach.

The Belgian L’Oréal-UNESCO For Women in Science Award 2024 for her important research into the metabolic evolution of cancer cells.




Was named Commander of the Order of the Crown in recognition for her cancer research and outreach.

In addition to the structural funding from the Flemish government, VIB sincerely values the financial support from various governing bodies and organizations that made this research possible.
Contributors include:
⬛ AACR
⬛ Alzheimer’s Association
⬛ Belgian Foundation Against Cancer
⬛ Belgian Queen Elisabeth Foundation
⬛ Bill & Melinda Gates Foundation
⬛ Brightfocus Association
⬛ Chan Zuckerberg Initiative
⬛ Cure Alzheimer’s Funds
⬛ EMBO
⬛ ERC
⬛ European Union
⬛ FEBS
⬛ Fund Baillet Latour
⬛ FWO
⬛ Generet Fund
⬛ HFSP
⬛ King Baudouin Foundation
⬛ Kom op tegen Kanker
⬛ Marie Skłodowska-Curie Actions
⬛ Michael J. Fox Foundation
⬛ National Sciences Foundation
⬛ NIH
⬛ Simons Foundation
⬛ Stichting Alzheimer Onderzoek
⬛ Target ALS
⬛ US Ministry of Defence
⬛ VLAIO
⬛ Wellcome Trust
⬛ Worldwide Cancer Research


Launched in 2017, the VIB Grand Challenges Program applies a ‘reverse translation’ approach – starting with unmet needs and then harnessing groundbreaking research to create solutions that benefit society. To date, it has funded 14 interdisciplinary and translational projects. In 2024, five ongoing projects continued to make progress in tackling major challenges with cutting-edge science. Three new initiatives were selected for funding.
The Spartacus project is testing whether early intervention with TNF inhibitors can cure spondyloartritis and eliminate the need for lifelong treatment. With patient recruitment for the clinical trial nearly complete, researchers are now analyzing biomarkers to identify which patients could benefit most. To facilitate the adoption of the findings, the project also develops health economic models demonstrating cost-effectiveness.
Meanwhile, the Ibcori project is developing an inhalable nanobody-based biologic that provides broad protection against influenza A. By targeting a highly conserved viral region, this treatment remains effective despite continuous strain evolution. Ongoing preclinical studies confirm its potential, and researchers are optimizing production and nasal delivery systems to ensure broad accessibility.
In the field of cancer treatment, the Pointillism 2.0 project aims to expand and validate potential biomarkers for immune therapy response in breast and skin cancer patients that were identified in the Pointillism 1.0 project. Breast and skin cancer biopsies and blood samples from various clinical studies are being validated using multi-omics technology. Initial data look promising, and in collaboration with Skyline Diagnostics, health technology assessment projects have been initiated.
Addressing rare diseases, BE.Amycon is uniting researchers, clinicians, and patients to improve care for peripheral amyloidosis. The project has already established a specialist network, an online information hub, and a standardized biobank protocol.
Lastly, Biopet is developing microbial fats as a sustainable alternative to animal fats in pet food. Researchers have engineered a high-fatproducing yeast strain and are now scaling up production while assessing the environmental benefits of this novel approach.

The Grand Challenges program continues to push scientific boundaries with three newly selected projects tackling major health and agricultural challenges.

The CUPIDGUT project explores the link between gut bacteria and Parkinson’s disease. Many patients experience digestive issues early on, and research suggests that the gut microbiome influences both symptoms and treatment response. Building on stool transplantation studies, CUPIDGUT aims to refine this approach and develop safe, effective guidelines. In the long term, this could pave the way for a bacterial pill, introducing beneficial microbes to improve patient outcomes.
In agriculture, SOY 2.0 focuses on making soy cultivation more sustainable and viable in cooler climates. While soy is a key plant protein source, current varieties require warmer conditions and nitrogen-fixing bacteria that do not thrive well in northern regions. The first phase of this research, GCP project Soy 1.0, identified native soil bacteria that enhance soy growth in Flanders.
Now, SOY 2.0 is conducting large-scale field trials together with ILVO and over 50 farmers to validate these findings, ultimately supporting local, climate-resilient soy production.
Meanwhile, the PID 2.0 project is facilitating the diagnosis of primary immunodeficiencies (PID). Building on previous breakthroughs, such as neonatal SCID screening and a newly developed gene panel for PID diagnosis, this next phase will validate and implement a fast, accurate interferon score test. This tool will enable quicker diagnoses and help doctors determine which patients could benefit from off-label treatments.

For many patients with primary immunodeficiencies (PID), ranging from infancy to adulthood, diagnosis can often come too late. Take the case of the patient who spent nearly a year battling relentless infections before doctors uncovered the underlying immune defect. By then irreversible damage had set in, leading to severe disability. Cases like these highlight the urgent need for better diagnostic tools to detect PID’s early and prevent severe complications.

The goal of this project is to map the molecular mechanisms that lie at the basis of primary immunodeficiency. At the same time, those mechanisms allow us to identify new markers.
This will not only facilitate early diagnosis, but we also intend to use that knowledge to develop new or better therapies for the treatment of immunodeficiency.
Rudi Beyaert Project Coordinator and VIB Group Leader, VIB-UGent Center for Inflammation Research
The VIB Grand Challenges PID 1.0 project has transformed how doctors diagnose and treat Primary Immunodeficiency (PID) disorders. These disorders comprise a group of more than 350 inherited conditions that impair the immune system, leading to life-threatening infections, autoimmunity, and even cancer. Early diagnosis and treatment are essential to prevent severe complications. Through innovative molecular profiling and biomarker discovery, the PID team has developed new diagnostic tools that have already begun saving lives.
One of the project’s most significant achievements was its role in establishing newborn screening for severe combined immunodeficiency (SCID) in Flanders. SCID is a life-threatening condition where babies are born with virtually no immune protection and is fatal for babies under the age of 1. Starting February 2025, all newborns in Flanders will be screened for SCID, allowing for life-saving interventions in the crucial early months of life.
An earlier achievement of the project was the use of the PID immunophenotyping platform to identify patients highly vulnerable to severe COVID-19 infections. Additionally, the project uncovered previously unknown PID families, leading to personalized treatment approaches for affected patients. These findings have been integrated into the biomarker panel at the Center for Medical Genetics at Ghent University Hospital, enabling, on a daily basis, more precise identification of rare immune disorders and tailoring treatments to individual patients.
Notably, throughout the project, researchers engaged closely with the PID patient community through annual Patient Days, ensuring that patient perspectives shaped the project’s direction and outcomes. Building on the success of PID 1.0, PID 2.0 has been approved to further refine and implement advanced diagnostic tools for PID, paving the way for even greater breakthroughs in immunodeficiency care.

Generating maximal data and insights from animal studies
VIB is fully committed to Replace, Reduce, Refine, and act Responsibly when it comes to animal research. While alternative methods such as organoids and organ-on-a-chip systems are used whenever possible, they cannot fully replicate the complexity of living organisms. In many cases, in vivo models remain essential for understanding disease mechanisms, drug responses, and biological interactions that simplified lab systems cannot capture.
By communicating openly and transparently about its approach, VIB aims to ensure that both the public and policymakers understand the role of animal studies in advancing medical research. In 2024, animal models played a crucial role in several of VIB’s groundbreaking studies unraveling the biological mechanisms defining health and disease.

Examples include:
⬛ VIB researchers observed how the estrous cycle in mice affects breast cancer’s sensitivity to chemotherapy, highlighting the importance of considering hormonal cycles in treatment strategies.
⬛ VIB scientists developed lipid-based nanoparticles to deliver therapeutic mRNA in mice, effectively stimulating their immune system to eliminate cancer cells. This approach paves the way for innovative cancer immunotherapies in humans.
⬛ Studies in mice revealed that certain E. coli strains adhere to intestinal cells and release DNA-damaging toxins, promoting colon cancer development. Understanding this mechanism opens avenues for targeted therapies and preventive strategies for people at risk.
⬛ By injecting human FUS protein aggregates into mice, VIB researchers demonstrated a prion-like spread of these aggregates, providing insights into neurodegenerative disease mechanisms. These results could guide future treatments aimed at halting disease progression in patients with amyotrophic lateral sclerosis (ALS) and frontotemporal dementia (FTD).
These recent examples highlight the critical role of animal research in advancing knowledge and developing new treatments.
At the same time, VIB recognizes the ethical concerns surrounding animal research and its researchers continuously work to minimize its use. One of the most impactful ways they do this is through technological innovation. More sensitive instruments, more relevant models, and more informative experimental approaches allow them to extract more data from fewer animals, significantly refining the animal models they use.
A striking example of this progress can be found in research on pancreatic islets — clusters of cells in the pancreas that regulate blood sugar levels. Historically, studying these tiny structures required a large number of mice due to technological limitations, particularly in mass spectrometry, necessitating the pooling of thousands of pancreatic islets to obtain sufficient data.
In 2018, a proteomics study in these islets required 156 mice. Today, we achieve the same results with just four, thanks to cuttingedge mass spectrometry tools now available at VIB,” explains Bart Ghesquière, Head of the VIB Metabolomics Core in Leuven. “These advanced instruments allow us to analyze individual pancreatic islets, each containing only approximately 750 cells, rather than needing thousands combined.

Furthermore, scientists now perform multi-omics analyses on a single sample, simultaneously capturing data on proteins, lipids, and metabolites. This not only maximizes the scientific value of each experiment but also dramatically minimizes animal use.

VIB researchers are developing innovative techniques that allow multiple genetic modifications to be done in a single experiment. Instead of creating separate knockout mouse lines, they first manipulate cells in vitro, introducing a range of genetic perturbations. These modified cells are then introduced into just a few host mice, creating a mosaic of different genetic alterations in a single organism.
“This method not only reduces the number of animals needed by about a factor twenty, but also enhances the depth of data obtained per experiment,” says Wouter Saelens, postdoc at the VIB-UGent Inflammation Research Center. “We can extract information on multiple genetic interactions simultaneously, unraveling complex biological pathways much more efficiently.”
As these examples illustrate, advancements in technology and science are transforming animal research. Experiments that once required a high number of animals can now be conducted with greater precision, requiring fewer animals while yielding far more data. This increased efficiency also opens the door to entirely new research questions that could not previously be explored. As a result, while some areas of research now require fewer animals, the overall need may not decline as sharply as expected. As long as there are diseases to cure and biological questions that cannot yet be answered through alternative methods, animal models will remain essential. In the meantime, VIB is committed to Replace, Reduce, Refine, and act Responsibly when it comes to animal research.
VIB researchers pursue bold ideas to discover disruptive insights that push science forward and increase our fundamental understanding of life. But VIB’s mission goes beyond the lab. The Innovation & Business team bridges the gap between science and practical applications by proactively teaming up with starting entrepreneurs as well as with established businesses.
Through strategic initiatives such as licensing intellectual property, launching spin-offs, and fostering partnerships within the life sciences ecosystem, VIB transforms scientific discoveries into impactful innovations. By providing researchers with the tools and support needed to commercialize their work, VIB drives economic growth, creates jobs, and attracts investment in the life sciences sector.
VIB’s New Ventures team, part of the Innovation & Business unit, plays a key role in transforming cutting-edge science into successful biotech companies. By leveraging Intellectual Property expertise, Business Development insights, and a strong investor network, the team helps secure the right partnerships and funding at critical moments. Over the past 25 years, VIB has built a solid reputation in the investment community, supported by a track record of high-impact start-ups.
Beyond company creation, New Ventures strengthen the broader biotech ecosystem, fostering innovation, economic growth, and job creation.
In 2024, VIB has successfully launched two spin-offs, despite a persistently challenging investment climate.
FLINDR THERAPEUTICS
While immunotherapy has transformed oncology, resistance remains a challenge. Flindr Therapeutics, the first joint Oncode-NCI-VIB spin-off that was launched in 2024, is advancing precision therapies to strengthen immune response and combat cancer, fueled by €20 million investment led by V-Bio Ventures and joined by new and existing investors and key collaborations.
Cancer is a notoriously difficult disease to treat, with conventional therapies often proving ineffective for patients. Immunotherapy has transformed cancer treatment, but resistance is still a significant hurdle. To address this, Flindr Therapeutics is pioneering a novel approach to precision oncology.
Flindr Therapeutics is using its ImmunoGram Drug Discovery Engine — a framework that systematically maps the key factors influencing a patient’s immune response to cancer. By leveraging this approach, Flindr Therapeutics has identified RNF31, a crucial regulator of protein stability in cancer and immune cells. Their research shows that inhibiting RNF31 can destabilize survival pathways in tumors, shifting the balance toward cancer cell death while also enhancing immune activity. This precision strategy enables the development of targeted small-molecule inhibitors that are tailored to patients most likely to respond.
Backed by a €20 million Series A investment from leading biotech investors, Flindr Therapeutics is advancing its lead candidate toward clinical trials. Bringing together expertise in functional genomics, immunotherapy, cancer biology, and small-molecule drug discovery, Flindr Therapeutics has built a solid foundation through collaborations with VIB, more specifically the group of Rudi Beyaert at the VIB-UGent Center for Inflammation Research, the Netherlands Cancer Institute, and the Oncode Institute. Together, they are paving the way for a new generation of precision cancer therapies designed to provide more effective, personalized treatment options for patients.


TRIM THERAPEUTICS
Trim Therapeutics was founded in 2024 by VIB and V-Bio Ventures. Trim Therapeutics focuses on the development of new gammasecretase modulators for the treatment of Alzheimer’s disease.
Gamma-secretase is one of the most genetically validated drug targets in Alzheimer’s, yet past efforts to develop drugs to modulate it have failed due to toxicity and off-target effects. Trim Therapeutics is taking a novel approach, leveraging the advanced know-how of the gamma-secretase complex at the Chávez-Gutiérrez lab (VIB-KU Leuven Center for Brain & Disease Research) and the translational expertise of VIB Discovery Sciences.
By combining novel cryo-electron-microscopy structures, molecular dynamics, and computational drug discovery, the company is developing novel gamma-secretase stabilizers with the aim to improve safety and efficacy. Backed by VIB, V-Bio Ventures, and the Gemma Frisius Fund, Trim Therapeutics is bringing fresh momentum to a once-elusive drug target.
The financial landscape in 2024 proved to be just as demanding as the previous year. Despite these hurdles, VIB spin-offs actively explored diverse avenues for follow-up financing. Encouragingly, several of these companies have made considerable progress, securing new funding rounds and forging strategic partnerships.
CONFO THERAPEUTICS
Confo Therapeutics has secured €60 million in Series B financing led by Ackermans & van Haaren, with participation from several new and existing investors. The funding will help support Phase 1 clinical trials for two wholly owned programs and advance two additional programs, including drug targets for obesity, to Investigational New Drug (IND) approval.
Confo Therapeutics’ proprietary ConfoBodies® platform unlocks the potential of G-protein coupled receptors (GPCRs), a crucial but notoriously difficult class of drug targets. By overcoming obstacles in GPCR targeting, the platform accelerates the discovery of precise small molecules and antibodies.
Confo Therapeutics is now expanding its portfolio for metabolic and rare endocrine diseases, with a focus on agonistic GPCR antibodies.


Protealis has raised €22 million in an over-subscribed B-round funding with investors reaffirming their confidence in the company’s approach, and underscoring the growing demand for sustainable, high-performance legume crops.
The company is at the forefront of developing locally adapted legume crops that strengthen regional food systems while minimizing agriculture’s ecological footprint.
2024 milestones include the launch of four additional soybean varieties for colder European climates (bringing the total to six new soybean varieties on the market), and promising yellow pea yield trials. The new funding will drive Protealis’ commercial expansion across key European markets and accelerate the development of its crop product portfolio and technology platform.
MUNA THERAPEUTICS
The number of patients with neurodegenerative diseases is growing, yet treatments lag. Muna Therapeutics is mapping brain resilience pathways to develop rootcause therapies.
In 2024, the company signed a new strategic research collaboration with GSK, which will accelerate their mission to bring hope to Alzheimer’s patients worldwide.
Millions worldwide suffer from neurodegenerative diseases like Alzheimer’s, Parkinson’s, and multiple sclerosis, but effective treatments are scarce. As the world ages, the urgency to uncover therapies that tackle the underlying biology of these conditions is intensifying.

A major challenge in developing new treatments has been understanding why some individuals remain cognitively resilient while others develop neurodegeneration. Muna Therapeutics is tackling this by using deep insights into human brain resilience mechanisms to identify novel drug targets and develop first-in-class small molecular therapies.
Their all-in-human target discovery platform maps molecular pathways in different brain cells to uncover mechanisms that drive both disease progression and resistance. This is combined with a small molecule drug discovery engine that integrates highresolution structural biology, AI-driven computational chemistry, and advanced cell-based screening to identify promising drug candidates.
One of the start-up’s scientific co-founders is Bart De Strooper, group leader at the VIB-KU Leuven Center for Brain & Disease Research. Through a new collaboration with GSK, Muna will leverage its MiND-MAP platform to identify and validate novel drug targets for Alzheimer’s disease, accelerating the advancement of its pipeline toward clinical trials.

TANAI THERAPEUTICS
GLP-1 drugs revolutionized obesity treatment, but challenges like muscle loss, injections, and long-term maintenance of weight loss persist.
VIB spin-off Tanai Therapeutic’s innovative approach has attracted additional support from investors like Novo Nordisk, a leader in obesity care.
Obesity is a global health crisis, affecting hundreds of millions and raising risks for diabetes and heart disease. Blockbuster drugs like Wegovy® (GLP-1 mimics) have revolutionized obesity treatment by curbing appetite, but they also come with challenges, including muscle loss and reliance on regular injections.
Tanai Therapeutics, a VIB spin-off launched in 2023, is pioneering an alternative approach. Tanai is developing an orally administered drug that selectively promotes fat loss while preserving muscle mass.
Their approach targets a genetically validated pathway that plays a key role in energy expenditure. Inspired by unique structural insights from the Savvides lab at the VIB-UGent Center for Inflammation Research), an intense collaboration was struck up between VIB Discovery Sciences and the lab to leverage this knowledge into an array of bioassays to support an extensive drug discovery campaign.
In addition to early backers V-Bio Ventures, Qbic, and VIB, Tanai Therapeutics has attracted further investment from Novo Nordisk and BioGeneration Ventures, bringing their total seed funding to over €6 million. The young startup has assembled a scientific advisory board composed of leading international experts in obesity research. With this funding and expertise, Tanai Therapeutics is progressing toward in vivo proof-ofconcept studies and advancing its mission of transforming obesity treatment.
biotope by VIB is an incubator program designed to support biotech start-up teams in transforming their agrifood innovations into investment-ready businesses. While the biotech sector is experiencing rapid growth, early-stage entrepreneurs often face significant challenges in finding the right environment to develop their ideas, secure funding, and build a sustainable company.
By providing specialized support, industry expertise, and access to VIB’s extensive network, biotope by VIB bridges the gap between groundbreaking research and commercial success. The program creates a fertile ground where start-ups can refine their technology, connect with investors, and accelerate their journey toward market impact.


By Stokedhouse
€22M raised in external funding 9 × leverage on initial investment collectively grew from 30 to 70 FTEs
The biotech sector is booming, but early-stage entrepreneurs often struggle to find the right environment to grow.
As a pre-seed investor and support ecosystem, biotope by VIB backs strong, diverse founding teams and fills this gap with:
⬛ Pre-seed investment: A select number of start-ups per cohort get €250,000 pre-seed funding to derisk their biotechnology.
⬛ Bespoke support: These start-ups receive intensive guidance.
⬛ Access to top-notch research infrastructure: State-of-the-art labs, greenhouses, test fields and related expertise.
⬛ Tech-driven focus: For start-ups with protectable biotech innovations validated in a lab setting.
Since 2022, 64 start-ups from 54 countries have joined the program’s signature basecamp. Thirteen companies were selected to receive €250,000 each. Collectively, they grew from 32 to 70 FTEs and raised €22 million in external funding — a 9x leverage on the initial investment.
Three start-ups, AmphiStar, Zymofix, and B’Zeos, have closed their early investment rounds in 2024, demonstrating the value of biotopeby VIB in helping biotech entrepreneurs turn technologies into success.

In 2024, VIB strengthened its position as a key driver of innovation by launching three new bio-incubators in Ghent, Leuven, and Brussels. These cutting-edge facilities provide biotech start-ups with the space, resources, and the collaborative environment needed to scale their innovations and accelerate their product or platform development.

In collaboration with PMV and with support from the European Union, VIB launched a 5,500 m² bio-incubator at Tech Lane Ghent Science Park. This facility accommodates 10 to 15 biotech start-ups, offering flexible lab and office spaces designed to foster collaboration. It also houses VIB’s central services and management team, positioning the institute at the heart of Flanders’ biotech ecosystem.
At Wetenschapspark Arenberg, VIB, KU Leuven, and Life Sciences Research Partners inaugurated Leuven’s fifth bio-incubator. Spanning 3,300 m², this state-of-the-art facility meets the increasing demand for specialized infrastructure within the life sciences cluster. Just months after opening, more than half of the space is already leased to start-ups, research groups, and established companies, creating a dynamic hub of expertise.
On the VUB campus in Etterbeek, VIB and VUB jointly launched the bio-incubator Brussels, a dedicated space for start-ups in biotech, pharma, and healthtech. Equipped with fully functional lab and office spaces, the incubator connects academic and industry partners to accelerate innovation. The VIB Nanobody® VHH Core, a pioneer in nanobody research for scientific and biomedical applications, was the first to move in.


VIB Agro-Incubator
VIB also continues to invest in agricultural biotechnology. The VIB Agro-Incubator in Nevele is a well-established facility, providing 3,500 m² of greenhouses, two hectares of field trial land, and shared lab spaces. In 2024, it supported the growth of Zymofix, a rising agri-tech start-up, and hosted strategic projects like BREEDIT and collaborations with Inari.
By expanding its incubator network, VIB provides biotech and agrobiotech start-ups with the space to grow, strengthening Flanders’ position as a leading hub for life sciences and biotechnology.
Jérôme Van Biervliet Managing Director VIB
Scientific breakthroughs don’t just change lives or help the environment — they also advance research itself. At VIB, collaboration is key to transforming discoveries into real-world impact, benefiting patients, society, and fellow scientists alike. Whether improving diagnostics for cancer treatment or making biotechnological tools more accessible, VIB researchers work across disciplines to push boundaries and share knowledge. These stories illustrate how innovation, openness, and teamwork accelerate progress for both society and science.
Access to high-performance yeast strains for biotech applications has long been restricted because of costly licenses and legal constraints. With OPENPichia, VIB-UGent is breaking down these barriers by providing a free-to-use, optimized yeast strain and toolkit, accelerating innovation in protein production worldwide. IMPACT STORY
Pichia pastoris (now known as Komagataella phaffii) is a workhorse in biotechnology, widely used to produce proteins for research, medicine, and industry. However, many commonly used Pichia strains are locked behind restrictive licensing agreements, making them expensive and difficult to access.
To break down these barriers, VIB-UGent’s
Callewaert lab launched OPENPichia, an open-access platform that provides a high-performance, license-free alternative for researchers and biotech companies worldwide.
A yeast strain for everyone With OPENPichia, VIB offers a freely available version of this powerful yeast, optionally with key genetic modifications that enhance protein production and secretion. Unlike traditional strains that require costly recurrent license agreements, OPENPichia can be used for both academic research and commercial applications for a small one-time fee, making it a game-changer for biotech startups, universities, and pharmaceutical companies.
An optimized toolkit
To help scientists get the most out of OPENPichia, the team also developed the OPENPichia MoClo kit: a modular cloning system that streamlines the generation of protein expression constructs. Based on the Golden Gate cloning technique, this kit enables fast and precise DNA assembly, allowing researchers to easily insert, remove, or swap genetic elements like promoters, signal peptides, and selection markers. This accelerates the development of new biotech applications, from therapeutic proteins to sustainable food production.
Global impact
Since its launch, OPENPichia has been adopted by over 40 institutions and companies worldwide, proving its value as a widely accepted open-science solution. By removing financial and legal obstacles, VIB is fostering a more collaborative and accessible biotech ecosystem, where impactful discoveries can happen faster and more equitably.
By offering this cost-effective, accessible, and high-performance yeast platform, we’re paving the way for the next generation of biotech breakthroughs, driven by open science and shared innovation.
Nico Callewaert VIB-UGent Center for Medical Biotechnology


For several years, PARP inhibitors have been available as an effective post-treatment option for certain ovarian cancer patients to help prevent relapse after surgery and chemotherapy. However, not all patients benefit from this therapy. Only those whose tumors show defects in homologous recombination — a key DNA repair pathway — are likely to respond.
This is where the HRD test (homologous recombination deficiency test) comes in. By analyzing tumor tissue samples taken during surgery, the test identifies whether a patient’s tumor has a genetic profile indicative of HRD and therefore if they would benefit from PARP inhibitor therapy.
Developing the HRD test is a nice example of how translational research ensures transmission and a quick translation of knowledge and innovative technology to diagnoses and treatments that benefit the patient.
Diether
Lambrechts
VIB-KU Leuven Center for Cancer Biology
Faster, cheaper, and more accessible
Until recently, Belgian hospitals relied on an expensive commercial test, requiring biopsy samples to be shipped overseas to the US. This process was costly, time-consuming, and created logistical challenges. Now, thanks to a close collaboration between researchers at the VIB-KU Leuven Center for Cancer Biology and gynecological oncologists at UZ Leuven, a locally developed alternative is available.
This homegrown diagnostic test delivers results faster and at a lower cost, allowing oncologists to make quicker and more informed treatment decisions. Patients who stand to benefit can get the right access, and those who are unlikely to respond to PARP inhibitors can immediately be guided toward better-suited therapies, avoiding unnecessary side effects.

From research to routine care
In May 2023, UZ Leuven became the first hospital in Europe to offer the in-house HRD test, and in 2024 the test was accredited by BELAC, the national body for laboratory accreditation. This means that other hospitals can now also send their patient biopsy samples to Leuven, and importantly, it has led to reimbursement of the test.
In 2024, over 400 patients from hospitals across Belgium had their biopsies analyzed through the HRD test. The successful knowledge transfer from research to clinical practice showcases the impact of translational research, creating practical solutions that make a difference in the lives of cancer patients.
Thanks to this test, we can avoid unnecessary expensive treatments and side effects. This is excellent news for patients with ovarian cancer and the result of an intense collaboration between doctors in the hospital and researchers from VIB and KU Leuven
Toon Van Gorp UZ Leuven
2 new spin-offs in 2024
€1.84 billion capital investment in total
+1,000 direct employees
Intellectual property
821 total number of patent applications
288 total active patent families
Industrial income
€138 million over the last 5 years
Inward investments
28 inward investments in 25 years
€2.9 billion capital investment in total
+1,100 employees
Incubator infrastructure
Bio-Incubator
Leuven
15,200 m²
29 companies
Bio-Incubator
Gent - Ardoyen
6,322 m²
13 companies
VIB Bio-Incubator
NV - Eiland
6,000 m²
4 companies
Bio-Incubator
Nevele
3,500 m² greenhouse
2 ha of fields
150 m² lab space
2 companies
Bio-Incubator
Brussels
1,250 m²
1 company
A thriving research environment is essential for attracting outstanding scientists and experts, driving scientific breakthroughs, and fostering innovation. VIB remains committed to strengthening research environments by investing in emerging technologies, state-ofthe-art facilities, professional development, and a dynamic, collaborative research culture.
VIB Technologies provides a cutting-edge techno-scientific ecosystem that supports the research community with top-notch equipment and expertise. Its core facilities offer shared access to advanced technologies, while the Expertise Units bring together specialists who provide in-depth guidance on complex data analysis and emerging methodologies in specific life science domains. Additionally, the Tech Watch Core continuously scans the horizon for new life sciences innovations, ensuring VIB stays at the forefront of technological advancements.

Collaboration is the foundation of VIB Technologies’ approach, with experts working closely alongside researchers from various life science disciplines. This synergy fuels both practical innovation and groundbreaking discoveries. In 2024, VIB Technology experts contributed to numerous highimpact publications and successful collaborations, two of these collaborative projects are highlighted on the following pages.
IMPACT STORY

Scientific breakthroughs often arise long before results appear in top-tier journals. For the De Rybel lab at the VIB-UGent Center for Plant Systems Biology, a recent Science publication on plant root development traces its origins to a close collaboration with the VIB Screening Core. This partnership underscores the crucial role of VIB Technologies in translating bold ideas into impactful discoveries.
The story began when Bert De Rybel envisioned screening for molecules that influence the orientation of cell division in plants. However, without advanced imaging technology, this vision remained out of reach. That changed in 2017, when the VIB Screening Core acquired the at-the-time brand new Opera Phenix High Content Imaging System from Revvity and recruited Vera Goossens, an expert in high-content imaging. This opened the door for De Rybel’s team to bring their concept to life.
Together, the VIB Screening Core and De Rybel’s lab developed an assay using tobacco BY2 cell cultures as a model system. The team meticulously fine-tuned imaging parameters, ensuring a clear visualization of cell division planes. This groundwork allowed them to screen 15,000 compounds, identifying several that interfered with cell division. The most promising hits were further validated, setting the stage for De Rybel’s subsequent research — culminating in a major discovery about SPL13’s role in regulating oriented cell divisions, and its potential impact on creating more climate-resilient crops.
According to Dominique Audenaert, head of the VIB Screening Core, this is just one example of how Core Facilities drive innovation. “Our high-throughput imaging and liquid handling systems allow us to process up to 10,000 samples per day. We collaborate on around ten projects of this scope annually, often laying the foundation for patents, publications, and further breakthroughs.”
By engaging the VIB Screening Core early in the research process, scientists maximize their chances of success. As Dominique puts it: “Our screen is just the starting point of an entire research project.” The collaboration with the De Rybel lab highlights the vital role of Core Facilities in accelerating scientific discovery, as the place where bold ideas, advanced technology, and expert support come together.
Our high-throughput imaging and liquid handling systems allow us to process up to 10,000 samples per day. We collaborate on around ten projects of this scope annually, often laying the foundation for patents, publications, and further breakthroughs.
Dominique Audenaert Head of the VIB Screening Core

Groundbreaking technology is revolutionizing cancer research, and VIB’s Tech Watch Core ensures that scientists stay ahead of the curve. By actively scouting and implementing emerging technologies, the Tech Watch team helps researchers integrate the latest tools into their work. One impactful example is MissionBio’s Tapestri platform, a high-throughput single-cell DNA sequencing system that enables researchers to analyze thousands of individual cells simultaneously, tracking tumor evolution at an unprecedented resolution.
Our ability to study tumor heterogeneity has been transformed. We can now map genetic mutations in thousands of cells at once, allowing us to better understand clonal evolution in leukemia and why certain subpopulations of cancer cells resist treatment.
Jan Cools
Group leader at the VIB-KU Leuven Center for Cancer Biology
Recognizing the potential of the platform, Tech Watch facilitated its implementation at VIB, making the institute one of the first in Europe to adopt this technology. Jan Cools, group leader at the VIB-KU Leuven Center for Cancer Biology, was the first research group to leverage the capabilities of this platform for acute lymphoblastic leukemia (ALL) research.
One of the key strengths of the technology is its flexibility in panel design, allowing researchers to customize sequencing panels for specific research questions. Cools and his team have now already designed 3 different amplicon panels targeting 300 to 400 regions in up to 110 genes frequently mutated in ALL. The goal was to capture single-nucleotide variants (SNVs) and small insertions and deletions (indels) while maintaining high coverage across thousands of cells.

By sequencing 5,000 to 8,000 individual leukemia cells per sample, the team identified clonal and subclonal mutations, revealing how leukemia evolves at a granular level. Their studies, published in Blood and HemaSphere, highlighted NOTCH1 and RAS mutations (KRAS, NRAS) as key drivers of leukemia progression in T-cell and B-cell ALL, respectively. The ability to track these genetic changes cell by cell gives scientists unprecedented insight into how cancers progress by accumulation and selection of mutations.
Beyond leukemia, other applications extend to CRISPR genome editing quality control, resistance mechanisms in cancer, and measurable residual disease tracking. By integrating high-throughput technologies into research pipelines, Tech Watch ensures that VIB scientists have access to state-of-the-art tools, transforming technological innovation into realworld impact, in this case for cancer patients.
In May 2024, VIB conferences and training were merged into one program, the VIB Training & Conferences program, to strengthen knowledge sharing, scientific excellence, and career development. This fully integrated initiative offers top-tier training, conferences, and workshops tailored to scientists and research support staff at every career stage.
The program covers a broad spectrum, from cutting-edge science and technology to leadership, communication, and career development. Indeed, beyond scientific expertise, essential skills like project management, team leadership, and clear communication are key to a successful career.

By fostering a culture of lifelong learning, collaboration, and research integrity, this program strengthens VIB’s global reach, attracts top talent, and reinforces Flanders as a leading hub for life sciences innovation — benefiting both academia and industry.
Evy Vierstraete Head of the VIB Training & Conferences Program
€149K
2,299
‘From 3D Light to 3D Electron Microscopy’, an event organized in March, gathered 170+ participants. The first VIB Spatial Omics Conference in June attracted over 400 attendees, featuring leading experts and pioneering research. Established conferences like Immuno-Oncology, Brain Mosaic, and Applied Bioinformatics continued successfully, while the Genome Engineering & Synthetic Biology Conference evolved to focus on synthetic biology.
149
VIB also expanded its training initiatives with new open educational materials on Python, Nextflow, Git, Research Data Management, and Generative AI, hosted on GitHub. Collaborations with SciLifeLab and ELIXIR enhanced FAIR training practices and bioinformatics education. Key events included summer schools in proteomics and single-cell transcriptomics, as well as hackathons on bioimage data analysis. Personal development programs covered stress prevention, disconnection, dignity at work, sustainability, leadership, and digital skills, alongside new e-learning modules on grant writing and tech transfer.
2,210
4,011
Diversity, Equity, and Inclusion (DE&I) are essential for fostering a workplace where everyone feels valued and supported. In 2024, VIB took concrete steps to strengthen its DE&I efforts, following the roadmap established in late 2023.
VIB developed two tailored internal workshops, one on Dignity at Work and the other on Active Bystander approach to empower VIB collaborators with specific knowledge and skills on how to work in this high-pressure, hyper-diverse working environment. Specific colleagues, mainly from HR, Communications and other support functions also received training on Diversity, Equity and Inclusion in the broader sense. There is also a dedicated page on VIB’s intranet that serves as a one-stop-shop for collaborators.
To create a more inclusive and safer work environment, VIB launched two Inclusive Communities focused on LGBTQIA+ advocacy and neurodiversity. These grassroots communities provide a space for colleagues to connect, share experiences, and support each other in a confidential and welcoming setting.
Throughout the year, we organized several thematic webinars and initiatives:
⬛ Appreciation Month (March)
Colleagues were encouraged to recognize and celebrate each other’s efforts through personalized appreciation cards.
⬛ Autism in the Workplace (April)
A webinar featuring experts and personal testimonies, offering insights and practical tips for supporting neurodivergent team members.
⬛ Allyship Campaign (June)
Raising awareness of the importance in supporting marginalized groups to create a more respectful and inclusive workplace.
⬛ Menopause at Work (October)
A session led by expert Kate Usher, discussing the impact of menopause at work and providing guidance on how to support colleagues experiencing symptoms like brain fog, anxiety, and sleep disturbances.
VIB continues to collaborate with external partners to promote diversity beyond our own walls. In 2024, we co-organized in the Pathfinder Mentorship Program, an initiative within the EU-LIFE network that supports female postdocs in advancing their careers. The program provides mentorship, addresses gender-specific challenges, and fosters a strong network of female scientists across 15 institutes in Europe. VIB has selected 3 women postdocs to participate in the program as mentees and has also delegated 3 mentors.
In 2024, VIB also collaborated with the Vlerick Business School, where 2 teams of management students worked on 2 projects: one to improve the accessibility of VIB conferences and events, and another to develop an eLearning on neurodiversity.
With the support of the Diversity & Inclusion Committee, which meets every two months, to advise and guide our initiatives, VIB remains committed to embedding DE&I into its culture. By fostering open conversations, supporting diverse talent, and championing inclusivity, we aim to create a workplace where every employee can thrive.
VIB attracts top scientific talent from around the world, with 41% of its staff being international. This trend is especially pronounced among postdoctoral researchers, where 68% come from abroad. Within the PhD student population, international researchers also outnumber Belgian colleagues. These figures have remained stable for over a decade, reflecting VIB’s strong international recruitment strategy and global research environment.
VIB actively promotes gender diversity in leadership positions, with women currently making up 33% of group leaders. While change is gradual due to limited turnover, upcoming retirements between 2024 and 2030 will create new opportunities to increase diversity. Women represent 61% of VIB’s PhD students and 50% of its postdocs, indicating a gender-balanced talent pool at the early career stage. Targeted measures will be key to supporting women in advancing to leadership roles.
VIB’s success stems from the passion, dedication, and expertise of its researchers. But what fuels their curiosity? What drives them to push the boundaries of science? This section highlights the people behind the breakthroughs — scientists whose ideas and innovations are shaping the future of life sciences. Discover their stories, inspirations, and the impact of their work.
For millions of people worldwide, getting a diagnosis for a rare disease remains an uphill battle. While genome sequencing provides answers for some, nearly 60% of cases remain unsolved. To tackle this challenge, the Wilhelm Foundation organized the Undiagnosed Hackathon, bringing together scientists, clinicians, bioinformaticians, and AI experts to tackle undiagnosed cases by analyzing comprehensive genetic data. Zakaria Eddafir, a PhD student at the VIB-UAntwerp Center for Molecular Neurology, played a key role at the event, helping to solve three cases and identifying a candidate variant in another. “As a bioinformatician, I’m usually working behind a screen on technical details. At the hackathon, it was eye-opening to see how the clinicians are so closely connected to the patients and deeply invested in the outcomes,” he shares.

multi-omics pipeline for long-read sequencing data, to uncover the genetic basis of early-onset epilepsy. His work combines bioinformatics and lab research to illuminate critical disease pathways, helping to close the diagnostic gap and provide much-needed answers for patients.

Erin Tranfield has joined VIB as the new Head of the BioImaging Core in Ghent, bringing a wealth of experience in advanced microscopy and core facility leadership. With a passion for imaging and technology, she is eager to support VIB researchers in applying cuttingedge techniques to their scientific questions. “I thrive in an environment where I can support the interesting research questions of the academic community by helping them apply the best possible technology to their question,” she says. Erin is particularly interested in Volume Electron Microscopy and spatial omics, which she hopes to further integrate into VIB’s imaging workflows.

Livia Di Crescenzo, a PhD student at the VIB-KU Leuven Center for Brain & Disease Research, is investigating the role of interneurons in autism. Her research focuses on a specific mutation in inhibitory brain cells and how it affects neural balance and social communication in a preclinical model.
Livia’s dedication earned her the Delacroix Award, which funds research into neurodevelopmental disorders. Passionate about neuroscience since childhood, Livia combines curiosity with determination to unravel brain complexities. “In science, it’s important to stay curious and embrace change,” she says. With her research, she hopes to deepen our understanding of autism and improve future treatments.
In 2024, Colinda Scheele and her team at the VIB-KU Leuven Center for Cancer Biology made major breakthroughs in breast cancer research, publishing two studies in Nature. One revealed how the menstrual cycle contributes to the spread of mutant cells in breast tissue, increasing cancer risk. The second found that chemotherapy effectiveness may vary depending on the menstrual cycle phase, highlighting the need for more female-focused medical research.

Building on these insights, Colinda has now been awarded an ERC Starting Grant to study how mutant cells in healthy tissue transform into cancer. She is developing an innovative gene-editing technology to investigate how the order of mutations affects cell behavior and tumor formation, with a focus on breast cancer.


For the third year in a row, Nikky Corthout, expert microscopist at the Leuven BioImaging Core, has been recognized in the Nikon Small World competition, which celebrates the beauty of microscopic imaging.
Her latest winning image captures the fine vasculature of a fruit fly brain, an unexpected discovery made while testing a new confocal microscope. This striking visualization has since inspired new research directions.
Xiao-Zheng Liu, a postdoctoral researcher at the VIB-KU Leuven Center for Cancer Biology, is dedicated to understanding how cancer cells adapt their metabolism to survive and spread. By uncovering their metabolic weak spots, she hopes to find new ways to prevent metastasis at an early stage.
Xiao-Zheng’s passion and expertise have earned her the Belgian L’Oréal-UNESCO For Women in Science Award 2024, recognizing her as one of Belgium’s most promising female scientists. With the grant, Xiao-Zheng will further her research into how metabolic changes drive cancer progression, bringing us closer to more effective treatments.
Beyond competitions, Nikky uses imaging to engage both scientists and the public, showcasing the power of microscopy. Whether in publications or a contest, she remains dedicated to revealing the extraordinary in the ordinary — one image at a time.

Sustainability goes beyond environmental responsibility. It encompasses the full impact of any activity on people and nature. VIB acknowledges both the positive and negative effects of its operations and aims to steer them in line with its mission.
In 2024, VIB took significant steps to define its sustainability priorities. The first priority was to measure VIB’s environmental footprint through carbon accounting. This provided a clear picture of the CO2 emissions across all VIB centers, helping to set targeted actions for reduction. At the same time, the sustainability coordinator engaged extensively with stakeholders to better understand where VIB’s research and operations influence society and the environment.
In 2024, the CO₂ emissions for all VIB centers, covering 17 locations, were calculated. The total footprint amounted to 36,892 tons of CO₂ equivalent for 2023 — comparable to 18,466 round trips between Brussels and New York.
The emissions were divided into three key areas:
Scope 1: direct emissions (e.g; heating and steam in our buildings)
Scope 2: indirect emissions from purchased energy (e.g. electricity)
Scope 3: indirect emissions from sources we do not own (purchased goods, their raw material extraction, production and transportation, employee commuting, business travel, product disposal)
To address this, the facility and sustainability team launched a roadmap for CO2 reduction, including investments in heat recovery, heat pumps, and solar panels. Efficiency measures such as optimizing LED relighting, implementing sustainable procurement policies, and running awareness campaigns on resource efficiency and energy use were also introduced. Through these measures, VIB is committed to reaching net-zero emissions by 2050.
In preparation for compliance with the Corporate Sustainability Reporting Directive (CSRD), VIB conducted a double materiality assessment to identify its most significant impacts, risks, and opportunities across the entire value chain.
This double materiality assessment has been the key starting point for our sustainability strategy. It provides a clear, data-driven foundation for setting priorities and taking targeted actions in three key areas: our own workforce, climate change, and the circular economy.
Wouter De Broeck Sustainability coordinator, VIB

This assessment follows the CSRDprescribed methodology, which requires organizations to evaluate sustainability from two perspectives:
Inside-out impact: How VIB’s core activities and operations affect nature and people.
Outside-in impact: How sustainability topics may financially impact VIB.
While financial considerations are typically less central to non-profits, this approach is mandated by CSRD to ensure a comprehensive understanding of sustainability risks and opportunities.
Environmental Social
Governance
To ensure a structured and inclusive approach, this process involved:
⬛ Expert evaluations of key sustainability topics based on the EU reporting standards (ESRS);
⬛ A broad stakeholder survey, ensuring that the prioritization of sustainability issues reflects the perspectives of those most engaged with VIB’s mission and operations;
Own workforce
Climate change
Circular economy
⬛ Impact scoring to determine the most critical sustainability actions;
Pollution Business conduct
Consumers & end-users
⬛ Final selection of VIB’s most material sustainability topics — our workforce, climate change, and the circular economy — which form the foundation of VIB’s long-term sustainability strategy.
Biodiversity & ecosystems
By leveraging this structured, stakeholderinformed, and CSRD-compliant approach, VIB ensures that its sustainability efforts are strategically focused, data-driven, and aligned with European standards, reinforcing its role as a responsible research institute.
Own workforce
Climate change
Circular economy
Pollution Business conduct
Consumers & end-users
Biodiversity & ecosystems
VIB’s eco teams play a key role in making sustainability actionable. In 2024, these teams launched multiple awareness campaigns and practical initiatives in their respective research centers. This could be for example reducing plastic waste or improving energy efficiency.
One impactful initiative was Plastic Awareness Month, hosted at VIB-UGent’s research buildings. The campaign was spearheaded by the eco teams and featured an exhibition on lab plastic waste, showing the environmental impact of consumables and the importance of efficient resource management. Researchers learned how small changes, such as switching to reusable glassware, optimizing sample sizes, and repurposing materials, can make a big difference.
The 5R campaign (Refuse, Reduce, Reuse, Repurpose, Recycle) provided practical strategies for minimizing plastic use in labs. The initiative culminated in the seminar "Improving science through sustainable practices," which brought together experts to discuss sustainable lab management. This initiative raised awareness and inspired several labs to commit to implementing plastic reduction plans for their daily operations.

An important tool to make the 5R principle tangible is the LEAF or Laboratory Efficiency Assessment Framework, a certification program that helps labs reduce their environmental impact through better resource management, energy efficiency, and other sustainable practices. Eleven groups signed up for the assessment program. Meanwhile three of them have achieved the Bronze level, the other groups still need to complete the process. Other initiatives included improving water management, enhancing traffic safety, and creating a platform for sharing used lab equipment. These local actions, combined with institute-wide policies, demonstrate that sustainability is a shared responsibility across all levels of VIB.
VIB, established in 1995, is a non-profit organization with a clear focus on scientific excellence and technology transfer. The institute is funded by a structural grant from the Flemish government and also draws on international and industrial resources to finance its research and operations.
Managing VIB’s diverse operations across multiple locations and scientific disciplines requires a well-structured organizational framework.

General Assembly
Board of Directors
Institutional Advisory Board
Directors’ Committee
General Management
Group Leader Committee
Postdoc Committee
Scientific Advisory Boards
As a non-profit organization, VIB’s highest governing body is the General Assembly (GA), which convenes at least once a year. During this annual meeting, the GA reviews and approves the activity report from the previous year and the budget for the forthcoming financial year. It also holds the authority to amend the organization’s statutes, approve financial accounts, and appoint or revoke its members. The GA consists of 41 representatives from across the Flemish ecosystem, including delegates from universities, scientific institutions, the life sciences industry, employee organizations, and the Flemish government.

The Board of Directors (BoD) is responsible for overseeing VIB’s operations and holds full authority over management decisions, as well as the organization’s extrajudicial representation. While the general management team handles daily operations, the BoD defines their mandate and evaluates their performance. The Board meets five times per year to guide the institute’s strategic direction and administrative matters.
It has also established the Good Governance Charter and ensures adherence to it. The BoD consists of 13 members, including six university representatives from Flanders, four members from the business sector, and two representatives from the Flemish government.
ACADEMIC REPRESENTATION
Katharina D’Herde
Emeritus Professor, UGent
Luc Moens
Emeritus Professor, UGent
Chris Van Geet
Vice-rector, KU Leuven
Gerard Govers Vice-rector, KU Leuven
Ronny Blust
Vice-rector, Universiteit Antwerpen
Peter Schelkens
Vice-rector, Vrije Universiteit Brussel
INDUSTRY REPRESENTATION
Ajit Shetty
Honorary chairman, Janssen Pharmaceutica
Staf Van Reet
Managing Director, Viziphar Biosciences
Leen Limbourg
Founding Partner, atoms & art
Griet Nuytinck
Managing Director, Anacura
Koen Quaghebeur Director, Globachem
GOVERNMENT OF FLANDERS
Dieter Deforce Professor, UGent
Bart De Moor Professor, KU Leuven
The Institutional Advisory Board (IAB) serves as a consultative body, providing strategic guidance on institutional policies. It plays a key role in enhancing VIB’s impact and global recognition in life sciences research. The IAB is composed of distinguished international scientists and industry leaders.
Detlef Weigel
Director, Max Planck Institute for Developmental Biology, Tübingen (DE)
Kay Davies
Dr. Lee’s Professor of Anatomy, Emeritus, Oxford (UK)
Huda Zoghbi
Director, Jan and Dan Duncan Neurological Research, HHMI Investigator and Professor Baylor College, Houston (US)
Peter Piot
Emeritus Director, London School of Hygiene & Tropical Medicine, London (UK)
Daria Mochly-Rosen
Professor, Chemical & Systems Biology –Stanford, Founder and co-director SPARK, Stanford (US)
Luc Debruyne
Former President of Global Vaccines, GSK, Brentford (UK)
Susan Gasser
Director, ISREC Foundation, Lausanne (CH)

Managing Directors Christine Durinx and Jérôme Van Biervliet oversee VIB’s daily operations, supported by the unit managers.
Christine Durinx
Managing Director VIB
Jérôme Van Biervliet
Managing Director VIB
Bart Lambrecht
Science Director VIB-UGent Center for Inflammation Research
Yves Van de Peer
Science Director VIB-UGent Center for Plant Systems Biology
Kris Gevaert
Science Director VIB-UGent Center for Medical Biotechnology
Patrik Verstreken
Science Director VIB-KU Leuven Center for Brain & Disease Research
Diether Lambrechts
Science Co-Director VIB-KU Leuven Center for Cancer Research
Jean-Christophe Marine
Science Co-Director VIB-KU Leuven
Center for Cancer Research
Kevin Verstrepen
Science Director VIB-KU Leuven
Center for Microbiology
The Directors’ Committee (DC) consists of the directors of VIB’s research centers, who act as the institute’s scientific leaders. Together with selected members from VIB HQ, they shape the institute’s scientific direction and priorities.
Jan Steyaert
Science Co-Director VIB-VUB Center for Structural Biology
Han Remaut
Science Co-Director VIB-VUB Center for Structural Biology
Rosa Rademakers
Science Director VIB-UAntwerp Center for Molecular Neurology
Sebastian Haesler
Science Director NERF
Stein Aerts
Science Director VIB.AI
Rik Audenaert CFO
Veerle Bogaert
HR Director
Geert Van Minnebruggen Technology Director
Inge Boets
Communications Director
Frederik De Coninck ICT Director
Marleen Vanstraelen Head of Science Policy

The Group Leader Committee (GLC) works closely with the DC, offering advice on matters that affect principal investigators (PIs). Composed of voluntary representatives from each VIB Center and a delegate from VIB Technologies, the GLC acts as a forwardthinking advisory body, addressing PI-related challenges and opportunities. It fosters open communication between group leaders, HQ, and the DC while advocating for solutions that enhance the research environment.
The Postdoc Committee (PDC) plays a vital role in fostering collaboration between VIB research centers and with industry partners. It provides postdoctoral researchers with networking opportunities and supports their career development by strengthening soft skills and facilitating professional growth.
Each VIB research center is supported by a dedicated Scientific Advisory Board (SAB), composed of international experts in the respective research fields. The SAB collaborates with science directors to shape the center’s strategic vision and assists in developing high-impact research programs.
VIB has implemented a ‘Good Governance Charter’, publicly available on vib.be. The principles of good governance at VIB undergo regular evaluation and refinement, ensuring alignment with both local and global advancements in this field and meeting the expectations of all stakeholders.
• Revenue & Allocation
Suzanne Tassierstraat 1 9052 Ghent
Belgium
Tel. +32 9 244 66 11 info@vib.be www.vib.be